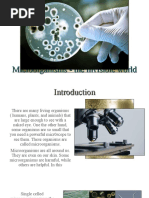

0% found this document useful (0 votes)
74 views3 pagesIntroduction 1
Microorganisms are tiny living organisms that cannot be seen without a microscope and can cause diseases as well as food spoilage. They are classified into five major groups: Bacteria, Viruses, Protozoa, Fungi, and Algae, and can be unicellular or multicellular. The study of microorganisms is known as Microbiology, and while some microbes are harmful, others are beneficial in food production.
Uploaded by
arifiqbal428Copyright
© © All Rights Reserved
We take content rights seriously. If you suspect this is your content, claim it here.
Available Formats
Download as PDF, TXT or read online on Scribd
0% found this document useful (0 votes)
74 views3 pagesIntroduction 1
Microorganisms are tiny living organisms that cannot be seen without a microscope and can cause diseases as well as food spoilage. They are classified into five major groups: Bacteria, Viruses, Protozoa, Fungi, and Algae, and can be unicellular or multicellular. The study of microorganisms is known as Microbiology, and while some microbes are harmful, others are beneficial in food production.
Uploaded by
arifiqbal428Copyright
© © All Rights Reserved
We take content rights seriously. If you suspect this is your content, claim it here.
Available Formats
Download as PDF, TXT or read online on Scribd